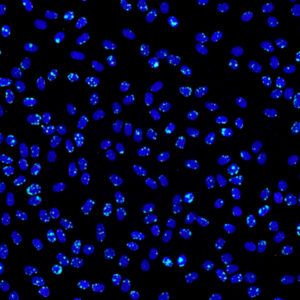

The recent release of the AI-Generated Image Detection feature by Proofig marks a significant advancement in the field of scientific image integrity. This feature focuses on detecting AI-generated images, specifically those created by the most widely used image generation model. The goal is to address the increasing threat of AI-generated images in scientific research, ensuring that such images do not compromise the integrity and authenticity of scientific publications.
Introduction to AI-Generated Images
What are AI-generated images, and how are they created?
AI-generated images are created using advanced algorithms that can produce realistic images based on input data. These algorithms, often referred to as generative models, learn from vast datasets and generate new images that mimic the patterns and features of the training data.
Example of an AI-Generated Image
Example of an AI-Generated Image: This image was created using the most widely used AI image generation model. Notice the realistic details and textures, which make it difficult to distinguish from a real image.
🔍 Challenge Yourself: Test your skills and try to identify which images are AI-generated. This quiz will help you understand the importance of detecting AI-generated images in scientific research.
Take the AI Image Detection Quiz
Why has the use of AI-generated images become more prevalent in recent times?
The use of AI-generated images has surged due to advancements in AI technology and the accessibility of powerful image generation models. These tools are now widely used in various fields, including entertainment, advertising, and increasingly, in scientific research, for generating visual content quickly and efficiently.
Understanding the Risks
What specific threats do AI-generated images pose to scientific research integrity?
AI-generated images pose several risks to scientific research, including the potential for fraud, misrepresentation of data, and the undermining of trust in scientific publications. These images can be used to fabricate or alter research data, making it difficult to distinguish genuine scientific findings from manipulated content.

Comparison of a Real Image and an AI-Generated Image: The image on the left is a genuine scientific image, while the one on the right is AI-generated. The AI-generated image mimics the patterns and features of the real image, highlighting the risk of data fabrication.
Can you provide examples of how AI-generated images have been misused in research?
There have been instances where AI-generated images were used to fabricate experimental results, leading to the publication of false findings. Such cases not only damage the credibility of the involved researchers but also mislead the scientific community and the public.
Proofig’s AI-Generated Image Detection Solution
How does Proofig’s AI Image Fabrication feature detect AI-generated images?
Proofig’s AI Image Fabrication feature leverages advanced algorithms to analyze and identify patterns unique to AI-generated images. By focusing on the most widely used image generation model, the feature can effectively detect synthetic images and flag them for further review.
What makes the currently most widely used image generation model the focus of this new detection capability?
The currently most widely used image generation model is targeted because of its prevalence and the sophistication of its outputs. Developing this capability is complex and time-consuming, but it addresses an imminent issue in scientific research. This is just the beginning; as the landscape of AI image generation evolves, so too will Proofig’s detection capabilities. Like an immune system adapting to new threats, Proofig is committed to continually evolving and expanding its feature set to include new models, ensuring we stay ahead in the race to protect scientific integrity.
Technical Aspects
What technologies and methodologies does Proofig use to identify AI-generated images?
Proofig uses a combination of machine learning, pattern recognition, and statistical analysis to detect anomalies in images that suggest AI generation. The system is trained on a vast dataset of known AI-generated images to recognize subtle differences that may not be apparent to the human eye.
How will Proofig ensure the detection feature stays updated with new AI models?
Proofig is committed to continuous improvement and adaptation. The system will be regularly updated with new datasets and retrained to recognize images from emerging AI models, ensuring it remains effective as technology evolves.
Implementation and Impact
How will this new feature be integrated into the existing Proofig platform?
The AI Image Fabrication feature will be seamlessly integrated into the Proofig platform, allowing users to easily upload and analyze their images as part of the standard workflow. The detection results will be presented alongside other integrity checks, providing a comprehensive overview of potential issues.
What immediate benefits can researchers and publishers expect from this feature?
Researchers and publishers will benefit from an additional layer of scrutiny, helping to prevent the publication of manipulated or fraudulent images. This not only protects the integrity of individual studies but also enhances the overall trustworthiness of scientific literature.
Future Directions
What are Proofig’s plans for enhancing this feature in the future?
Proofig plans to continually refine and expand the AI Image Fabrication feature, incorporating new AI models and improving detection accuracy. The aim is to stay ahead of the curve and provide the most reliable tools for ensuring scientific integrity.
How does Proofig plan to handle the continuous evolution of AI image generation technologies?
Proofig will maintain a proactive approach, constantly monitoring advancements in AI image generation and updating the detection algorithms accordingly. This ongoing vigilance will ensure that the system remains capable of identifying even the most sophisticated AI-generated images.
User Guidance
How will users interact with the AI Image Fabrication feature?
Users will benefit from the AI Image Fabrication feature as it will be automatically integrated into the existing Proofig platform. Upon uploading their manuscript, the system will automatically check for AI-generated images as part of the standard workflow. Any suspected images will be highlighted for the user to review within the context of other integrity checks.
Industry Perspective
How do you see the role of AI-generated image detection evolving in the broader context of scientific research?
The detection of AI-generated images will become increasingly crucial as AI technology continues to advance. By implementing robust detection systems like Proofig’s, the scientific community can safeguard the authenticity of research and maintain public trust in scientific findings.
What feedback have you received from the scientific community regarding this new feature?
The scientific community has expressed strong support for the AI Image Fabrication feature, recognizing its importance in combating the growing threat of AI-generated image manipulation. Researchers and publishers alike appreciate the added layer of security it provides.
This comprehensive article introduces the concept of AI-generated images, explains the associated risks, and details how Proofig’s new AI Image Fabrication feature addresses these challenges, ensuring the continued integrity of scientific research.